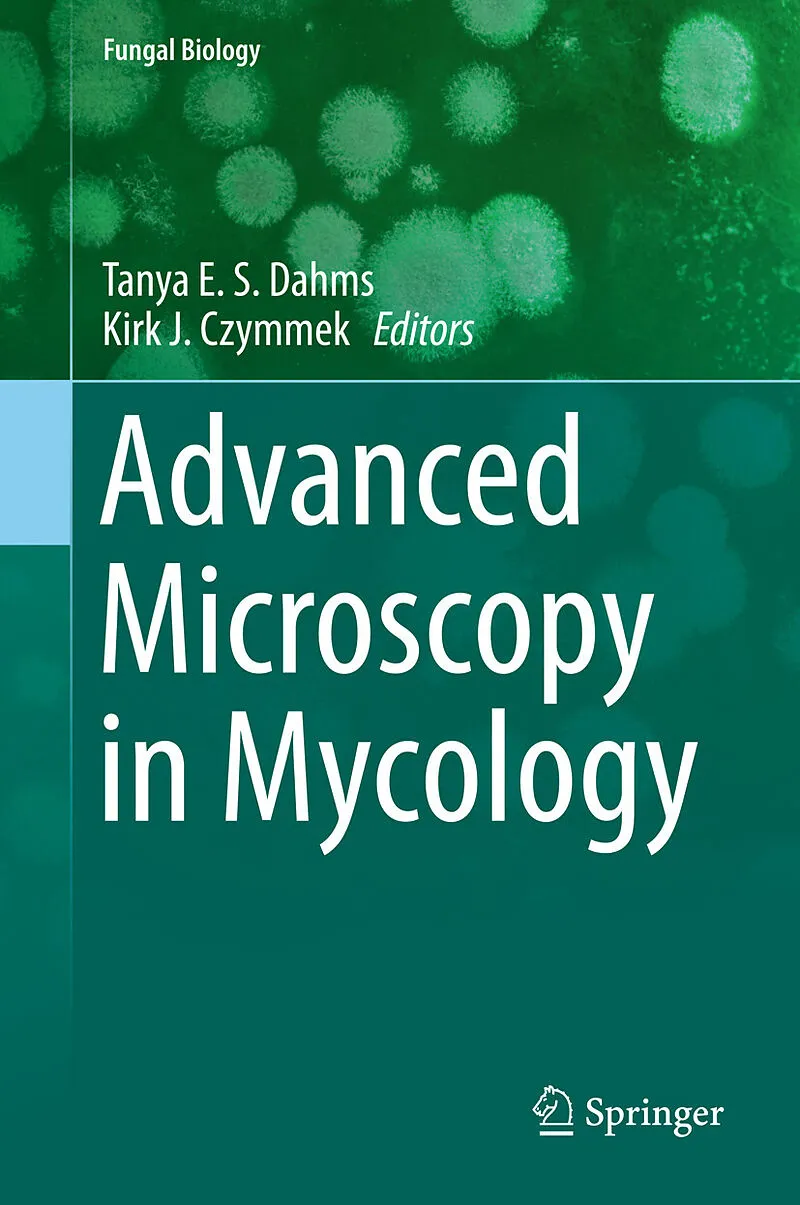

Willkommen. Schön, sind Sie da!
0

Advanced Microscopy in Mycology
Beschreibung
This volume provides insight into the principles underscoring various advanced microscopy methods and how they have been, or have the potential to be, applied to mycology. Offering a comprehensive overview of the confocal principle, confocal laser scanning mi...Format auswählen
- E-Book (pdf)CHF 118.90
- Fester EinbandCHF 122.00
E-Book (pdf)
CHF118.90
Fester Einband
CHF122.00
CHF118.90
Download steht sofort bereit
Kein Rückgaberecht
